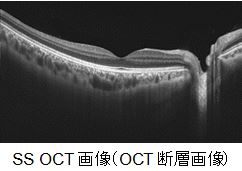

光干渉計測を利用した3次元眼底像撮影装置DRI OCT Triton を発売
多機能眼底カメラを備え眼底深部まで撮影できる高侵達 OCTを臨床の現場へ株式会社トプコン(本社:東京都板橋区、代表取締役社長:平野 聡)は、SS OCT (SS OCT: Swept Source Optical Coherence Tomography)と眼底カメラの複合機、3次元眼底像撮影装置 DRI OCT Tritonを2015年2月に発売します。

SS OCTとカラー眼底撮影、FA (蛍光眼底血管造影眼底撮影)、FAF (自発蛍光眼底撮影)*1を組み合わせた複合機、「DRI OCT Triton / Triton plus」が満を持して登場します。
DRI OCT Tritonは、OCT撮影の光源に中心波長1μmのSwept Source (波長掃引光源)*2 を用いており、次の特徴を備えています。
- 波長1μm帯光源の高い組織侵達性により、眼底深部の観察や中間透光体に混濁がある場合での観察を容易にします。
- 高品位な波長掃引光源を用いることで断層画像の深さ方向の劣化を低減し、硝子体から網膜・脈絡膜深部まで一枚の断層画像を均質な画質で映し出します。
- 100,000 A-Scan/ 秒の高速な撮影スピードにより、眼球運動の影響を受けにくい高精細なOCT画像の取得を可能にします。
- 撮影光は完全に不可視光であるため、患者さんが撮影光を目で追うことによる撮影中の位置ずれが発生しにくくなります。
また、DRI OCT Tritonの持つもう一つの大きな特徴は、次のように種々の眼底写真撮影機能を備えていることです。

- カラー眼底撮影
- FA: フルオレセイン蛍光眼底血管造影
- FAF: 自発蛍光眼底撮影
- デジタルレッドフリー
DRI OCT TritonはSwept Sourceがもたらす先進性のみならず、同時に種々の眼底写真 (カラー, FA, FAF) を撮影できる利便性を兼ね備えています。DRI OCT Tritonは研究領域のみにとどまらず、臨床の現場においてその能力を最大限に発揮すると期待しています。
販売名 :3次元眼底像撮影装置 DRI OCT Triton
医療機器認証番号 :226AABZX00146000
*1 FA, FAFはともにTriton plusのみの機能になります
*2 撮影光源の一種です
【OCT測定方式の歴史】

OCT(光干渉断層像)が眼科応用された当初はタイムドメインと呼ばれる干渉信号の取得方式が用いられていました。本手法ではスキャンスピードが参照鏡の可動速度によって制限されており、OCT信号のスキャン速度は約400 A-Scan/ 秒*3と、実用性の面からは厳しい点がありました。2006年に当社は世界に先駆けてスペクトラルドメインOCT (3D OCT-1000)の販売を開始しました*4。初期のタイムドメイン方式と比較するとスキャン速度は飛躍的に向上し、短い測定時間内での高解像度撮影が可能になりました。さらに2012年には、波長掃引(Swept Source)光源を採用したDRI OCT-1 Atlantisを発売し、世界最速*5のスキャン速度、100,000A-Scan/ 秒を実現しました。今回発売するDRI OCT Tritonは、DRI OCT-1 Atlantisと同様に光源にSwept Sourceを採用し、世界最速の座を引き継いでいます。
【特長】
■ 世界最速 100,000 A-Scan/秒
当社の現行機(3D OCT-2000) に比べて約2倍のスキャン速度となる世界最速 100,000A-Scan/ 秒でOCT断層像を撮影できます。
■ 中心波長1μm Swept Sourceによるメリット
中心波長1μmの光源を利用するSwept Source光源は、スペクトラルドメインOCTの光源波長(中心波長840nm)と比較して組織侵達性に優れ、同時にOCT画像の上方(硝子体側)、および下方(強膜側)の感度の劣化が少ない特徴を有しています。この特徴により、深さ方向2.6mmの広い範囲において均一な画質で断層画像の取得が可能であり、硝子体側から、網膜、脈絡膜、強膜の領域を高精細に撮影することが可能です*6。また、中心波長1μmを使用することにより白内障など水晶体混濁による散乱の影響を軽減できるため、中間透光体に混濁のある眼の状態であっても眼底断層像を高感度で撮影できます。

*3 他社製初期モデル
*4 当社調べ
*5 当社調べ、商用利用の機器に限る
*6 眼球後極部撮影時
■不可視スキャン
中心波長1μmの波長を持つ光源によるもうひとつのメリットは、撮影する光が眼に見えないこと、すなわち不可視の状態で撮影が可能になることです。そのため患者さんがスキャンラインを眼で追うことなく撮影を行うことができます。
■SS OCTと種々の眼底写真撮影機能の融合
高精細なOCT撮影とともに、カラー眼底写真、デジタルレッドフリー、FA: 蛍光眼底血管造影、FAF: 自発蛍光眼底写真の撮影を1台で行うことができ*7、臨床における利便性を高めています。
■ 眼底画像からOCT撮影位置を指定 (眼底ガイド撮影)
従来のワークフローに加え、撮影した眼底画像上でOCT撮影を行う部位を指定することが可能です。これまで個別に行われてきた、眼底カメラで撮影された画像を参考にしたOCT撮影位置指定、というルーチンをDRI OCT Triton一台で実現します。また、フォローアップ撮影により同じ部位の経過観察を行うことができます。
■ OCT画像の撮影位置再現性機能の向上 – SmarTrack TM システム
ソフトウェアのアルゴリズムの改善により、眼底画像からOCT撮影の位置を指定する場合や、経過観察において前回と同じ部位のOCT画像の撮影を行う場合の位置再現性を向上*8しました。
■ 正常眼データベースを搭載
撮影した結果を定量的に評価出来ることがOCTを用いた診察における大きな長所です。この長所をさらに活かす機能として、DRI OCT Tritonにも正常眼データベースを搭載しています。撮影した結果と、当社において蓄積した正常眼データベースを比較することにより、疾患の早期発見を促すよう医師の診断をサポートします。
■ 前眼部のOCT画像も高精細で撮影
DRI OCT Tritonシリーズでは専用アタッチメント(別売付属品)を使用することで前眼部の観察・撮影が可能です。前眼部に最適な光学設計と中心波長1μmによる組織侵達性とが相乗し、高精細な前眼部断層像の撮影が可能

*7 FA, FAFはTriton plusのみ
*8 当社前モデルと比較
■ 販売情報
販売名 :3次元眼底像撮影装置 DRI OCT Triton
医療機器認証番号 :226AABZX00146000
発売時期 :平成27年2月
■ 主な仕様
| 眼底観察・撮影 | |
|---|---|
| 撮影種類 | カラー、FA1)、FAF1)、レッドフリー2)、IR |
| 撮影画角 | 45° |
| 30°相当(デジタルズーム) | |
| 作動距離 | 34.8mm |
| 撮影可能瞳孔径 | 通常時:φ4.0mm 以上 |
| 小瞳孔径時:φ3.3mm 以上 | |
| 眼底断層像観察・撮影 | |
| スキャン範囲(眼底上) | 横方向 3~12mm |
| 縦方向 3~12mm | |
| スキャンパターン | 3D スキャン |
| 直線状スキャン(Line-scan/ Cross-scan/Radial-scan) | |
| スキャンスピード | 100,000 A-Scan/秒 |
| 横方向分解能 | 20μm |
| 深さ方向分解能 | 光学:8μm |
| デジタル:2.6μm(複数回撮影時) | |
| 撮影可能瞳孔径 | φ2.5mm 以上 |
| 眼底観察・撮影/眼底断層像観察・撮影 | |
| 固視標 | 内部固視標:ドットマトリクスタイプ有機EL |
| 提示位置切換・調整、提示方法変更可能 | |
| 周辺部固視標:内部固視標提示位置に連動し提示 | |
| 外部固視標 | |
| 被検眼視度測定範囲 | 視度補正レンズなし :-13D ~ +12D |
| マイナス視度補正レンズ使用時3) :-12D ~ -33D | |
| プラス視度補正レンズ使用時3) :+11D ~ +40D | |
| 前眼部観察・撮影4) | |
| 撮影種類 | IR |
| 作動距離 | 17mm |
| 前眼部断層像観察・撮影4) | |
| 作動距離 | 17mm |
| スキャン範囲 | 横方向 3~16 mm |
| (角膜上) | 縦方向 3~16 mm |
| スキャンパターン | 3D スキャン |
| 直線状スキャン(Line-scan/Radial-scan) | |
| スキャンスピード | 100,000 A-Scan/秒 |
| 固視標 | 内部固視標、外部固視標 |
| 電気的定格 | |
| 電源電圧・周波数 | 交流100V 50-60Hz |
| 電源入力 | 250VA |
| 寸法及び質量 | |
| 寸法 | 320~359 (W)×523~554(D)×560~590 (H)mm |
| 質量 | 21.8kg、23.8kg(plus) |
1) FA撮影、FAF撮影は、plusのみ可能
2) カラー撮影した画像を画像処理し、疑似的にレッドフリー撮影画像として表示するデジタルレッドフリー
3) マイナス視度補正レンズ使用時・プラス視度補正レンズ使用時、スプリットオートフォーカス及びスプリット輝線による手動フォーカスを用いることはできない
4) 前眼部観察・撮影は前眼部アタッチメント使用時のみ可能